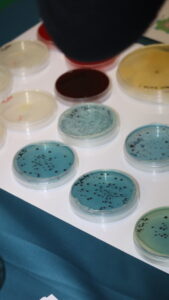

Retour sur la Fête de la science
Comme chaque année de puis 9 ans, le village des sciences s’est posé sur le site de Montpellier de la Faculté d’Éducation les 4 et 5 octobre 2025 ; Des ateliers ouverts aux enfants des écoles ont aussi été proposés sur les sites de Montpellier, Nîmes et Perpignan.
Village des sciences sur le site de Montpellier

Le Village des Sciences a été officiellement inauguré en présence de Véronique Dominguez-Guillaume, Rectrice déléguée pour l’Enseignement supérieur, la Recherche et l’Innovation, Isabelle Parrot, Vice-Présidente de l’Université de Montpellier déléguée à la Relation Science-Société, et Agnès Robin, Adjointe au Maire de Montpellier déléguée à la Culture et à la culture scientifique.
Un moment fort qui marque le lancement d’un week-end placé sous le signe de la curiosité, du partage et de la découverte scientifique pour tous les publics !

Fête de la science sur le site de Perpignan
Comme chaque année les étudiants de Licence ont organisé des ateliers qu’ils ont mis en œuvre auprès d’élèves d’écoles de la ville.


Intelligence et communication chez les êtres vivants
L’intelligence est perçue comme le propre de l’humain, pourtant, elle se manifeste de multiples manières tant chez les autres animaux que chez les végétaux. A travers une investigation qui les conduira à la fabrication d’une maquette, les élèves étudieront des modes de communication chez les animaux pour découvrir de nouvelles manifestations du vivant et relations entre les être vivants.
L’intelligence artificielle : quand les machines aident à apprendre
Pour les plus petits (cycle 1), place au jeu et à la découverte sans écran avec un atelier “débranché” pour comprendre l’IA autrement.
Pour les plus grands (cycles 2 et 3), l’expérience continue avec deux temps forts : une activité débranchée pour réfléchir et une autre avec tablettes en main pour explorer l’IA en action !



Fête de la science sur le site de Nîmes
Le site de Nîmes a proposé aux élèves des écoles primaires du Gard des ateliers de découvertes et d’activités scientifiques.

Communication en réseau social : la collaboration et la coopération animale chez les abeilles
Des ateliers ludiques et pédagogiques pour explorer la diversité des formes d’intelligence présentes dans la nature et les sociétés humaines. Une belle manière d’allier créativité, pédagogie et engagement scientifique, en favorisant la rencontre entre le monde universitaire et le jeune public.
Ces ateliers ont été conçus et mis en œuvre par des étudiants de Licence Pluri MEEF et sont encadrés par les formateurs en sciences du site du Nîmes.

